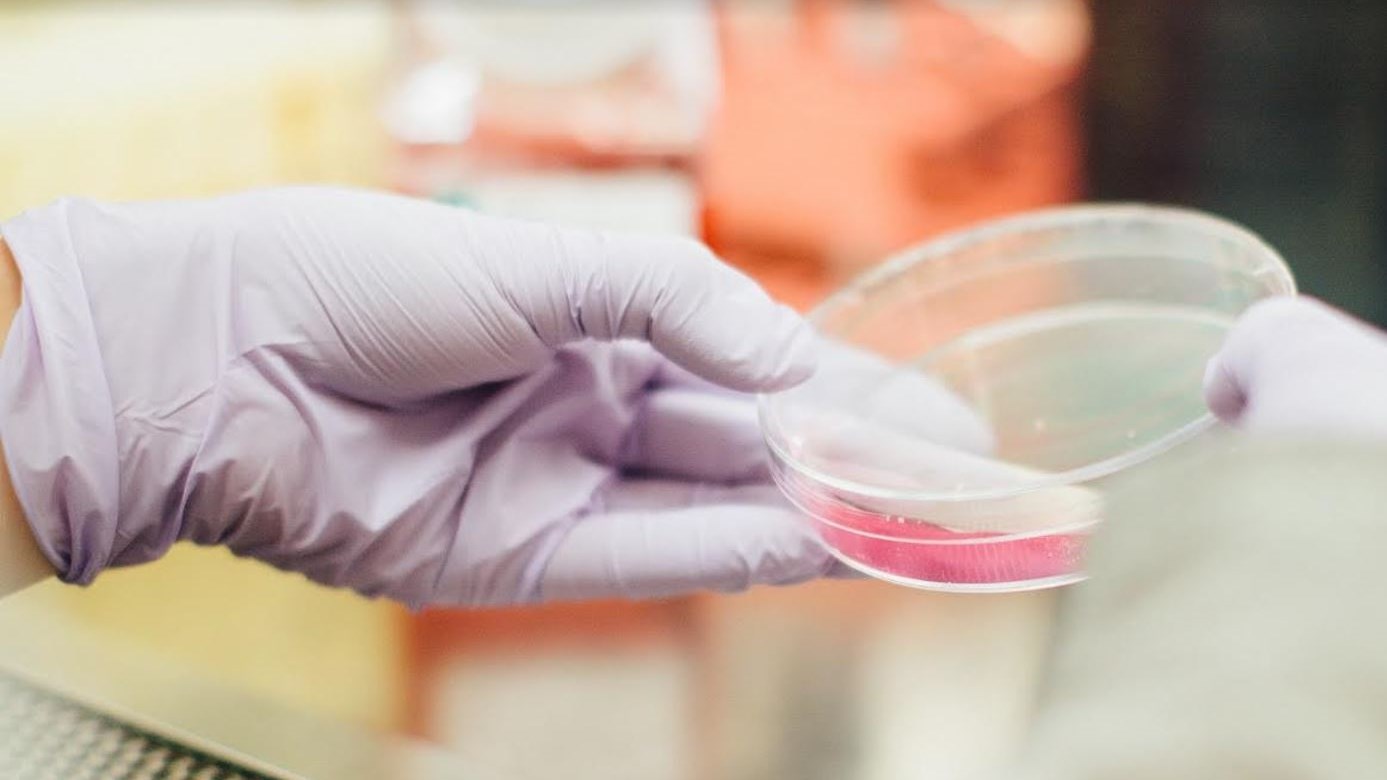
Ελληνίδα επικεφαλής σε σημαντική μελέτη που αποκαλύπτει νέα διάγνωση για τη νόσο Αλτσχάιμερ

Επιστήμονες στη Βρετανία, με επικεφαλής μια Ελληνίδα ερευνήτρια, ανέπτυξαν ένα πειραματικό μη επεμβατικό τεστ αίματος για την έγκαιρη διάγνωση της νόσου Αλτσχάιμερ. Στη μεγαλύτερη και πιο εμπεριστατωμένη μελέτη του είδους της, οι ερευνητές έχουν αναλύσει δείγματα αίματος για να δημιουργήσουν ένα νέο και μη επεμβατικό τρόπο για να βοηθήσουν στη διάγνωση της νόσου του Αλτσχάιμερ και στη διάκριση μεταξύ διαφορετικών τύπων νευροεκφυλιστικών διαταραχών.
Διαβάστε περισσότερα στο ellines.com
Δείτε επίσης:
Έλληνας αστρονόμος στην ομάδα που ανακάλυψε το πιο γρήγορο πάλσαρ στο γαλαξία μας
Έλληνας ερευνητής στο Ινστιτούτο Max Planck
Οι 10 πιο εντυπωσιακές πόλεις σε κορυφές λόφων στην Ευρώπη
Οι 10 ομορφότερες παραλίες στη Χαλκιδική
Έλληνας οδήγησε τις αρχές στην κατάσχεση αρχαίου αγγείου από το Μουσείο Met